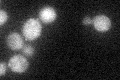
YOR275C
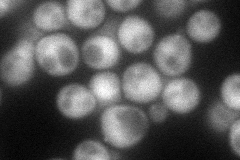
YOR275C
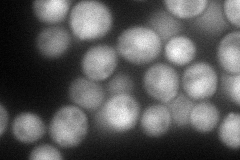
YOR275C
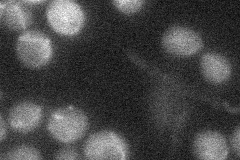
YOR275C
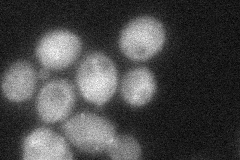
YOR275C
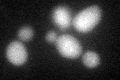
YOR275C

View description
Protein involved in proteolytic activation of Rim101p in response to alkaline pH; PalA/AIP1/Alix family member; interaction with the ESCRT-III subunit Snf7p suggests a relationship between pH response and multivesicular body formation
Localization:
Intensity:
Fold change:
Significance:
-
C’ GFP library in SD
cytosol27.35 -
N' NOP1pr-GFP in SD
cytosol,punctate69.2057 -
N' TEF2pr-mCherry in SD
punctate,nucleus96.5504 -
N' NATIVEpr-GFP in SD
punctate18.9959 -
N' TEF2pr-VC and Cyto-VN in SD
cytosol41.5454 -
C’ GFP library in SD+DTT
cytosol29.591.08No -
C’ GFP library in SD+H2O2

cytosol28.831.05No -
C’ GFP library in Starvation Media

cytosol26.430.96No -
C’ GFP library on the background of Pup2-DaMP

cytosol -
C’ GFP library on the background of CCT mutant

cytosol31.04251.13456No
